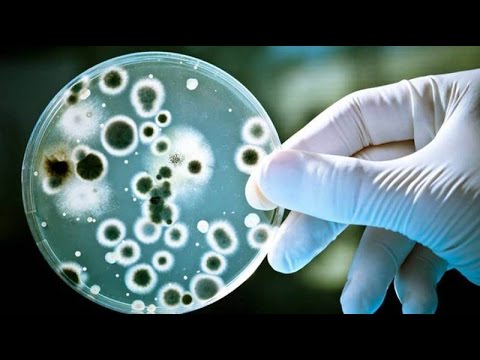

📹 Похожие видео
Ацетон у детей. Что делать, если у ребенка ацетон? Доктор Комаровский | Вопрос докторуСкачать

В помощь мамам при острицах и других паразитах у детей! Кирилл Вершилов. АврораСкачать

АЦЕТОН Чем помочь! Кирилл Вершилов АврораСкачать

Короткая инструкция по очистке от грибков Кирилл ВершиловСкачать

Как понизить ацетон у детейСкачать

Основная причина НЕУСВОЕНИЯ питательных веществ - поломанный ЖКТ! Кирилл Вершилов АврораСкачать

💥 Дополнительные видео
КАК СПРАВИТЬСЯ С КАТАРАКТОЙ. Кирилл Вершилов АврораСкачать

Аритмия - схема реально помогает! Кирилл Вершилов АврораСкачать

Что вызывает ЗАКИСЛЕНИЕ организма у детей! Вершилов Кирилл. АврораСкачать

Роль ФАЙБЕР-ХИТ в программе очистки! Кирилл Вершилов АврораСкачать

ТРИ ШАГА в очистке ЛИМФЫ! Кирилл Вершилов АврораСкачать

Что делать, чтобы пища стала лекарством! Кирилл Вершилов Аврора Одесса 2018Скачать

Снижаем ацетон у детей - быстро и правильноСкачать

Ацетон у ребенка: первая помощь / Запрещённые и разрешённые продукты при ацетоне у детейСкачать

"Давай сделаем это вместе" - работает всегда! Кирилл Вершилов. АврораСкачать

Как облегчить женщине РОДЫ! Кирилл Вершилов АврораСкачать

Кирилл Вершилов: Я всё делаю, почему не получается?Скачать

Симптомы появления ГРИБКА! Кирилл ВершиловСкачать
Когда ехать с ацетоном в больницу? - Доктор КомаровскийСкачать


